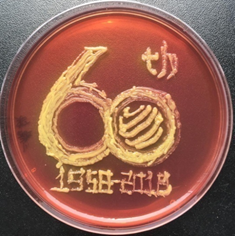

发布时间:2021-03-18 浏览量: 作者:李玉 来源: 生物工程学院
一、课程简介
《微生物学》是生物工程、食品科学与工程、制药工程等专业的必修课,也是专业核心课,自1958年建校开始,我校就在发酵工程专业开设了《微生物学》,经过几代人的不断改革创新,逐渐形成了承上启下的教学内容和完整的课程体系,2009年被评为天津市级精品课程,2019年获批天津市线下一流本科建设课程,2020年被认定为首批国家级线下一流本科课程。
为充分发挥课堂的主渠道育人功能,课程教学团队始终坚持把立德树人作为根本任务,把思想政治工作贯穿到课程教学全过程,不断传播积极向上的正能量,强化思想政治引领,提高学生的人文素养、科学素养和认知能力,培养学生勇于创新的科研精神和精益求精的工匠精神,培养具有家国情怀,有责任、有担当的轻工行业工程技术人才和社会主义接班人,为早日实现中国梦贡献力量。
二、课程思政的教学设计
在课程教学设计过程中,充分挖掘与本课程相关的思政资源,把做人、做事的道理,社会主义核心价值观的要求,以及民族产业复兴的伟大任务等融入到微生物学课堂教学中。
1.改革教学模式,引导学生树立正确的人生观和价值观,鼓励学生自信、自强
《微生物学》课程现在采用大班授课小班辅导的上课模式,解决了以往学生与老师的交流障碍问题,小班辅导采用灵活的一对一解答、分组讨论等方式,为学生答疑解惑,并积极引导学生善于思考、乐于实践,并不断将科研项目、企业生产实际等内容引入课程教学中,激发了学生的学习兴趣,同时增进了老师和学生的关系和感情,课下大家畅所欲言,便于老师进行一对一的指导和帮助,让他们更加自信,更富有激情的学好自己的专业,做好自己的职业规划。






2.理论教学和实验教学、创新实践紧密结合,培养学生的团队合作意识和科研创新精神
授课过程中,通过引入生产实践案例首先让学生熟知学习每个章节的目的和重要性,引导学生利用所学知识,解决实际生活和生产问题,积极参与各项创新竞赛活动,培养团队合作精神,提高自身综合素质。如很多学生参加我们教研室组织承办的微世界艺术大赛以及全国的培养皿艺术大赛,将中国的传统文化、艺术瑰宝、建校60周年、抗疫英雄、疫情防控等元素与微生物的培养结合起来,体现出了微生物的魅力和学生的家国情怀,展现了新一代大学生的创新意识和积极向上的精神面貌。

3.挖掘典型教育案例和代表性人物的贡献,增强学生的民族自豪感和爱国主义情怀
挖掘国内或本校知名学者的先进事迹和伟大成就,如在第一章绪论中加入汤飞凡、陈騊声、魏喦寿、方心芳、金培松等老一辈科学家对我国微生物学发展的伟大贡献,并详细讲解中国发酵工业的先驱、我校发酵教研室主任——金培松先生的感人事迹,充分激发学生的民族自信心和自豪感,启发学生对于科研工作的忘我付出、舍小家爱大家的奉献精神,培养学生的爱国主义情感和使命感。


4.探讨微生物技术发展现状和存在问题,培养学生的职业责任感和使命感,并努力奋斗,坚持不懈
《微生物学》课程在教学内容上更加侧重于工业生产应用,在每个章节都会介绍相关发酵产品和生物技术的研究进展,如在讲解代谢控制发酵时,我们主要以氨基酸的发酵为例,而我校的张克旭教授、陈宁教授团队在国内氨基酸相关产品的发酵生产中做出了突出的贡献,那目前国内外的氨基酸生产还面临着哪些问题和挑战呢?如何解决?在第八章微生物遗传育种中,讲到基因工程方法构建重组菌株,我们以“诺维信公司诉山东隆大公司、江苏博立公司侵犯专利权纠纷案”为例,国内的酶制剂生产企业如何能够突破诺维信、杰能科等国外酶制剂企业的技术壁垒,构建出属于我们自己独立知识产权的高产菌株和生产技术?如何实现酶制剂的低成本生产,解除进口依赖?如何利用我们学到的知识服务我们的民族企业?结合这些问题,我们给学生布置作业,检索文献,结合大班讲解和小班讨论,让学生意识到学习的重要性和自身的价值,增强责任感和使命感,树立远大目标,并为之努力、奋斗,为行业的发展、国家的富强贡献力量。


三、在课程思政方面的教学特色与创新
1.采用“大班授课、小班辅导讨论”的教学模式,与学生紧密联系、倾心交流,以老师的人格魅力、教授们的优秀成果、以及老一辈科学家们的伟大创举和奉献精神感染和引导学生,培养学生的爱国主义情怀和艰苦奋斗的优良品格。
2.利用“问题导向”、“时政案例”,引入科技发展前沿、实际生产问题,激发学生的学习热情和创新能力,增强自信心和和使命感,立志投身轻工行业,服务社会,造福人类。
3.积极组织微世界艺术大赛,鼓励学生参与各种创新竞赛活动,培养学生应用理论知识分析问题、解决问题的能力,利用微生物本身以及相关的技术方法解决人类健康、疫情防控、食品安全以及环境污染等问题,培养学生关爱健康、珍惜生命、洁身自爱,时刻牢记“绿水青山就是金山银山”的科学内涵。